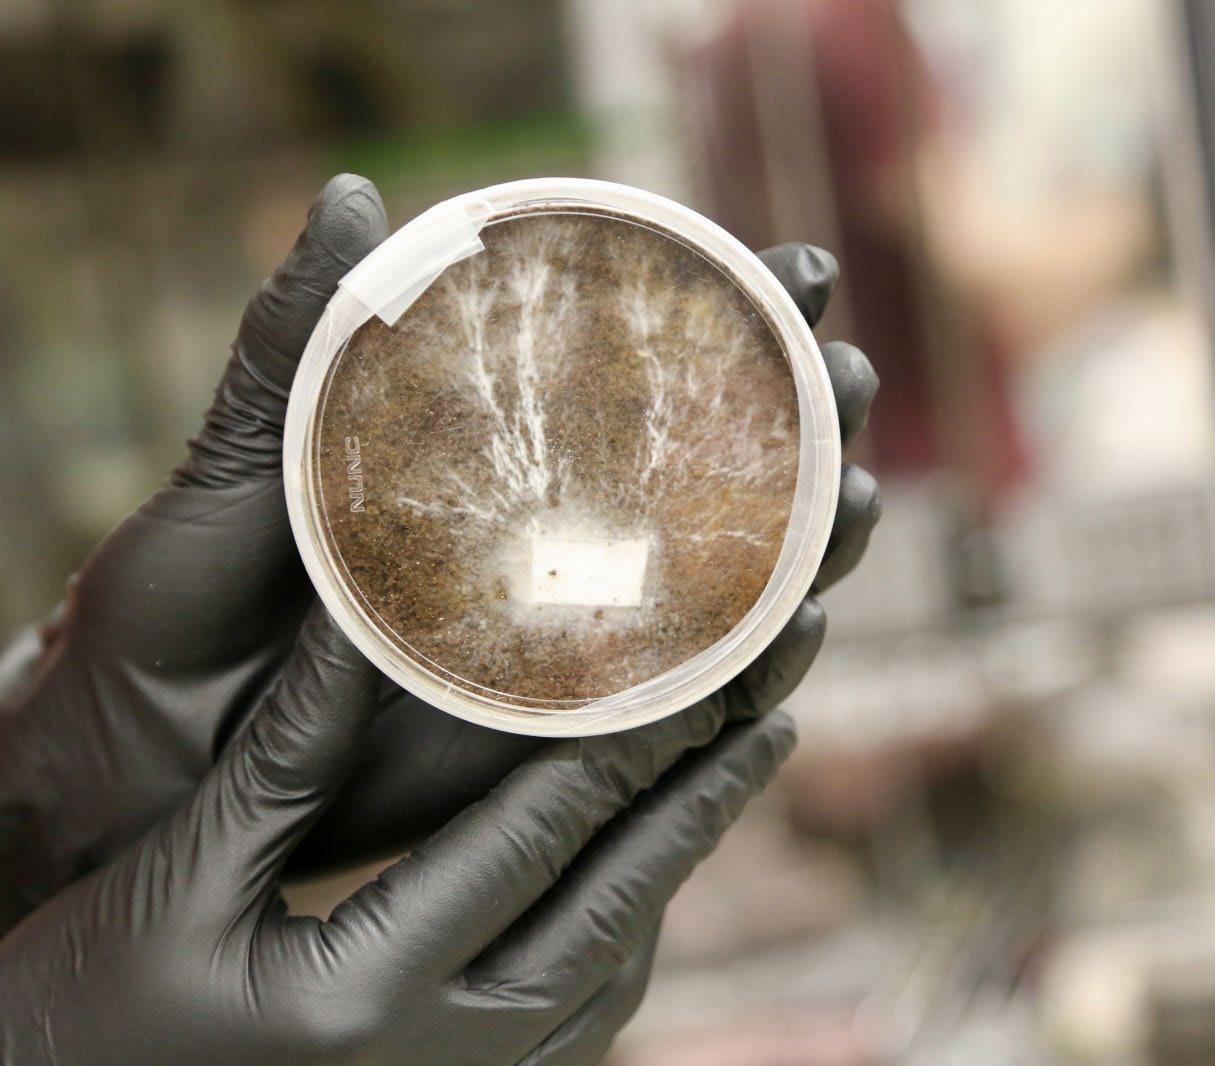

19 minute read
Zetsteen van baggerspecie
from IM20201NL
Duurzame dijkbekleding:
Zetsteen van baggerspecie
Advertisement
Waterschap Scheldestromen is onder andere verantwoordelijk voor de veiligheid van alle dijken en duinen in Zeeland. Om haar kerntaken duurzamer en slimmer uit te voeren is Scheldestromen continu op zoek naar innovatie-partners. Momenteel bereidt het waterschap een dijkverzwaring voor bij het dorp Hansweert. Binnen dit project onderzoekt Scheldestromen, samen met innovatiepartner NETICS, een manier om de benodigde nieuwe steenbekleding van de dijken te verduurzamen door deze van baggerspecie te maken.
Waterschap Scheldestromen beheert 424 km aan primaire waterkeringen. Momenteel wordt de veiligheid van deze keringen beoordeeld aan de hand van de nieuwe normering WBI2017. Het primaire dijktracé Westerscheldedijk rond Hansweert met een lengte van 4,5 km moet volgens deze wettelijke normering extra veilig zijn, gezien de lage ligging van het dorp in een kleine kom. Zodoende bleek na het berekenen en controleren van de dijk dat hier een versterkingsopgave wacht om deze dijk toekomstbestendig te maken. De dijk bij Hansweert is opgenomen in het Hoogwaterbeschermingsprogramma (HWBP). Binnen deze alliantie van de waterschappen en Rijkswaterstaat wordt gewerkt aan de versterking van de primaire waterkeringen zodat deze in 2050 voldoen aan de wettelijke normen vastgelegd in de Waterwet. Naast het ‘gewone’ werk stimuleert het Hoogwaterbeschermingsprogramma (HWBP) dat waterschappen innoveren. Daarmee hoopt het kosten te verminderen van de enorme opgave die Nederland te wachten staat: circa 1100 km dijken versterken tot 2050. Scheldestromen heeft voor Dijkverzwaring Hansweert een innovatieprogramma opgezet, voor zowel procesals technische innovaties.
Volledig circulair
Waterschap Scheldestromen heeft als doelstelling om in 2025 volledig energieneutraal te zijn en in 2050 volledig circulair. De productie en het transport van zetsteen voor dijken is daarbij een aandachtspunt. Voorheen kwamen deze stenen uit groeves op honderden tot duizenden kilometers afstand. De laatste decennia worden de blokken vooral in betoncentrales geproduceerd. Eén van de technische innovaties die Scheldestromen in het programma van Hansweert oppakt is het toepassen van het afvalmateriaal bagger bij de productie van zetsteen voor de dijkbekleding. Door

Kloostermop

Breuksteen

Megablok
baggerspecie te gebruiken als bouwmateriaal hoeft geen beton meer te worden geproduceerd en getransporteerd. Met de NETICS innovatie ‘GEOWALL Zetsteen van baggerspecie’, wordt de grondstof gewonnen uit de directe omgeving en zal zo een belangrijke bijdrage leveren aan minder CO 2 -uitstoot. De zetsteen is eenvoudig her te gebruiken doordat de baggerspecie met technieken weer is terug te winnen. Dit zorgt voor meer circulariteit, niet alleen in Zeeland maar wereldwijd.
Bouwen met bagger
Samen met het Nederlandse ingenieursbureau NETICS, dat al verschillende innovaties binnen het thema ‘bouwen met bagger’ ontwikkelde, start Waterschap Scheldestromen in 2020 het onderzoek. Het idee werd eind 2019 al genomineerd voor de Waterinnovatieprijs in de cate
gorie Waterveiligheid. De zetstenen van bagger zijn innovatieve blokken, die volgens de door NETICS gepatenteerde GEOWALL techniek* zullen worden geproduceerd. Deze techniek maakt het mogelijk om hoogwaardige bouwelementen te ontwikkelen uit laagwaardige baggerspecie. Deze bouwelementen ontstaan door vermenging van natuurlijke binders met het gebaggerde sediment die vervolgens, door middel van een specialistische pers werkend onder zeer hoge druk, mechanisch gestabiliseerd worden tot blokken. Deze blokken kunnen in verschillende groottes, vormen en sterktes geproduceerd worden, afhankelijk van de gewenste toepassingseisen en de randvoorwaarden die volgen uit het ontwerp van de constructie. De uitdaging hierbij is om met het specifieke basismateriaal, de unieke soort baggerspecie die lokaal gewonnen wordt, de gewenste producteigenschappen te verkrijgen. Voor verschillende toepassingen zijn er door NETICS in het verleden al diverse blokvormen van baggerspecie ontwikkeld, zoals de kloostermop (30 x 14 x 9 cm), breuksteen (40 x 40 x 40 cm) en megablokken (160 x 80 x 80 cm).
Gesloten keten
Door te bouwen met bagger ontstaat een gesloten circulaire keten, waarbij geen afval wordt gegenereerd en bouwprojecten duurzamer worden en bijdragen aan een circulaire economie. Dankzij de GEOWALL-techniek hoeft baggerspecie niet langer als afval beschouwd te worden, maar juist als een gift van de natuur. Nu en in de toekomst kunnen veel primaire grondstoffen hierdoor vervangen worden in tal van constructies, waaronder dijken, oevers,


dammen, golfbrekers, maar ook gebouwen, geluidsschermen, kabelgoten en infrastructuur. Elke toepassing stelt andere eisen aan de kwaliteit en vorm van het blok. In de afgelopen zeven jaar is techniek in de basis ontwikkeld en zijn de eerste eenvoudige blokken van baggerspecie gemaakt. Zo zijn er inmiddels oevers, kademuren en kleine gebouwen met deze blokken gemaakt. De volgende stap is het geschikt maken van de blokken voor toepassingen in haven- en kustgebieden als duurzaam en goedkoper alternatief voor breuksteen of als afdeklaag van een dijk. Doordat de blokken moeten voldoen aan strenge wet- en regelgeving komt hier veel bij kijken en wordt tijdens de pilot in Hansweert uitgezocht en getest hoe de blokken hieraan kunnen voldoen.
Techniek
Het ontwikkelen van de zetsteen klinkt misschien als een eenvoudige klus, maar schijn bedriegt. De toepasbaarheid van baggerspecie hangt namelijk sterk samen met de milieukundige en geofysische kwaliteit van het materiaal. De milieukundige kwaliteit van baggerspecie wordt gekenmerkt door de mate van

verontreinigingen en bepaalt of de wetgeving toestaat dat deze baggerspecie ergens mag worden toegepast. De geofysische kwaliteit anderzijds is bepalend voor de verwerkbaarheid van de bagger en is dus een maat voor de potentie van baggerspecie om hergebruikt te worden als bouwstof.
Om van natte baggerspecie naar sterke en duurzame blokken te gaan, dient in elk geval de geofysische kwaliteit aanzienlijk verbeterd te worden. Hiervoor zijn verschillende opwerkingstechnieken beschikbaar welke grofweg zijn onder te verdelen in vier hoofdmethoden:
Biologische stabilisatie = verbeteren structuur door natuurlijke rijping/ landfarming Fysische stabilisatie = verbeteren korrelverdeling door additie ander type grond Scheikundige stabilisatie = verhogen bindingskrachten door toevoeging vezels & binders Mechanische stabilisatie = verbeteren pakkingsgraad onder invloed van compactie
Naast het stabiliseren van de baggerspecie tot blok zijn ook de juiste dimensies en vormen van belang. Grote blokken

zijn lastiger te maken, doordat ook de kern van het blok gestabiliseerd moet worden. Daarnaast is het geven van een vorm aan een blok cruciaal om bijvoorbeeld dijkbekleding te kunnen maken, maar geeft dit tegelijkertijd ook een enorme uitdaging in het productieproces.
Pilot zetsteen Hansweert
Voor de innovatie ‘Zetsteen van baggerspecie’ zal er zowel een laboratoriumonderzoek als praktijktest worden uitgevoerd. Dit betekent dat eerst onderzocht wordt hoe de baggerspecie maxi
maal kan worden gestabiliseerd om aan de eisen de voldoen. Vervolgens wordt deze stabilisatiemethode opgeschaald en getoetst in zowel een proefopstelling op schaal alsook in een werkelijk stuk dijkvak op ware grootte. Onderzocht wordt of de ontwikkelde techniek voldoet aan de randvoorwaarden en eisen. Door een continue monitoring wordt nagegaan hoe de zetstenen zich houden bij diverse type belastingen en onder wisselende weersinvloeden.
Tijdens de eerste fase wordt in het laboratorium de meest geschikte sta
bilisatiemethode bepaald. De nieuw te ontwikkelen zetsteen zal grotendeels, voor naar schatting 80 procent, gemaakt worden van lokaal gebaggerd hoog organisch sediment. Om de stenen van elk type baggerspecie te kunnen produceren worden er unieke recepten ontwikkeld. Hierbij zijn toevoegingen mogelijk van primaire en secundaire binders. Ook de werking van puzzolanen, geopolymeren, vezels zoals cellulose en tal van andere beschikbare binders wordt onderzocht. Naast de scheikundige stabilisatie is ook de mechanische stabilisatie een essentieel onderdeel van het productieproces.

Door de steen onder een hoge drukkracht samen te persen krijgt deze de juiste vorm, sterkte en duurzaamheid. Het bepalen van het juiste recept en de drukkracht gebeurt tijdens hoogwaardige praktijktests. Uiteindelijk wordt de zetsteen getest op sterkte, dichtheid, stabiliteit, erosiegevoeligheid, vervorming, structuur en uitloging. Ook wordt nagegaan of de ontwikkelde zetsteen

geschikt is om op grote schaal, met de huidige uitvoeringstechnieken en machines, te worden gebruikt.
De GEOWALL Zetsteen wordt ook buiten het laboratorium uitgebreid getest en onderzocht op eigenschappen als sterkte, duurzaamheid, fysische eigenschappen en vormvastheid. De pilotproef op werkelijke schaal is ook van belang om te In 2020 zetten NETICS en Waterschap Scheldestromen de eerste stappen om zetsteen voor dijken te produceren uit baggerspecie. Wanneer uit labonderzoek is bepaald hoe en waarmee het GEOWALL Zetsteen van baggerspecie het best geproduceerd kan worden, wordt in 2021 een proeflocatie op een bestaande dijkbekleding ingericht. Het doel is om al in het HWBP project Dijkversterking Hansweert, dat tussen 2022 - 2024 wordt uitgevoerd, profijt te hebben van deze innovatie. Na Hansweert kan men deze techniek toepassen in vele dijkverzwaringen in Nederland, maar ook daarbuiten.
onderzoeken of de uitvoering haalbaar is en of de zetsteen geschikt is om alle optredende belastingen en klimaatschommelingen te kunnen doorstaan. Naast het onderzoeken van de uitvoering is het van belang om de ecologische waarde van de zetsteen van baggerspecie te onderzoeken. Zo zal er bijvoorbeeld op de zetstenen van baggerspecie algengroei en ontwikkeling van zeewier plaatsvinden, hetgeen ook gemonitord wordt. Naast dat dit in veel gevallen zorgt voor een esthetische meerwaarde, blijkt ook de ontwikkeling van unieke aquatische milieus voor een ecologische diversiteit te zorgen. Een goed voorbeeld van ‘building with nature’.
* GEOWALL is een door NETICS gepatenteerde technologie (patent: NL B1 2012739)

Ir. J.J. Pieterse (Waterschap Scheldestromen), ir. H.H.M. Ekkelenkamp (NETICS), drs. L.J. Kranenburg (NETICS)

Beton-schuim-glas sandwich
Afgelopen januari besteedde detail-online.com aandacht aan het onderzoeksproject ‘Composietverbinding in sandwichelementen van hardschuimbeton’ van de Universiteit van Siegen. Het onderzoek richtte zich op een nieuw type sandwichelement voor gevels, gemaakt van sandwichpanelen van beton, hardschuim en glas.
Thermische isolatie-composietsystemen zijn niet nieuw. Ze bestaan meestal uit een dragende laag van gewapend beton, een thermische isolatielaag van hardschuim en een vaak gladde gevelbekleding. De verbinding tussen deze afzonderlijke lagen is meestal mechanisch en wordt uitgevoerd met bevestigingsankers. Het weglaten van deze bevestigingspunten zou interessant zijn in termen van materiaalbesparing en productiecomplexiteit. Daarnaast zou de thermische isolatie er op vooruit gaan en zouden de panelen wellicht dunner kunnen worden uitgevoerd. En dat is precies wat de onderzoekers van Siegen hebben onderzocht. In een onderzoeksproject in samenwerking met de leerstoel Structural Design aan de Universiteit van Siegen werd een nieuw type sandwichconstructie ontwikkeld waarbij de glaslaagbekleding en de isolatielaag worden verbonden met een versterkingslaag van gewapend beton zonder mechanische verankering. De trekkrachten en schuifkrachten, worden in de scheidingslagen tussen de drie materialen uitsluitend door een hechtlaag overgedragen.
Er zijn uiteenlopende tests uitgevoerd om de hechting te karakteriseren tussen enerzijds de verschillende hardschuimpanelen en anderzijds het betonnen draagmateriaal. In het laatste geval is gekeken naar zowel ‘gewoon’ beton (ordinary performance concrete, OPC) als ultra sterk beton (ultra-high performance beton, UHPC). De hardschuimpanelen bestonden uit geëxpandeerd polystyreen (EPS), geëxtrudeerd polystyreen (XPS) en polyurethaan (PUR) en hadden verschillende oppervlaktestructuren. Er zijn verschillende oppervlakken in de composietverbinding tussen het glas en het isolatiemateriaal onderzocht, net als de hechting tussen het beton en het isolatiemateriaal. Uit de analyse van de breukoppervlakken valt vooral het belang van een hechtprimer op. Het stijve schuim verwerkt met een hechtingsbevorderaar heeft aanzienlijk kleinere poriën in hogere aantallen bij het grensvlak met het glas. In vergelijking met hardschuim zonder hechtingsprimer, resulteert dat in een groter effectief oppervlak voor de overdracht van hechtings- en schuifkrachten, wat op zijn beurt weer leidt tot een sterkere binding tussen het glasoppervlak en het hardschuim.
Het project bevestigt volgens de onderzoekers de technische haalbaarheid van sterke glas-hardschuim-beton-sandwichelementen. Verdere tests zullen moeten uitwijzen hoe het materiaal zich gedraagt onder mechanische en klimatologische spanningen.
Detail-online>
Universität Siegen>

Bakstenen geproduceerd met mycelium, tuinafval en houtsnippers als onderdeel van het myco-architectuurproject. Vergelijkbare materialen kunnen worden gebruikt om onderkomens op de maan of op Mars te bouwen (Bron: 2018 Stanford-Brown-RISD iGEM-team/NASA)
Zijn paddenstoelen het constructiemateriaal voor Mars?
Wonen op de maan of op Mars vraagt om nieuwe architectonische ideeën. Hoe komen de bouwmaterialen daar bijvoorbeeld? En hoe moet je er überhaupt mee bouwen. Eerder dit jaar sprak NASA Techbriefs met dr. Lynn Rothschild, de hoofdonderzoeker van het zogenaamde ‘myco-architecture project’ van het NASA’s Ames Research Center. Het project onderzoekt een innovatieve manier om onderkomens op de maan en Mars te maken. Het idee is simpel: breng de materialen niet naar Mars, want dat vergt enorme energiekosten, maar kweek ze gewoon daar met paddenstoelen, of beter: met de myceliumdraden.

Het ultieme doel van het ‘myco-architectuurproject’ is om compacte onderkomens te kunnen bouwen op ver afgelegen plaatsen zoals Mars. En dat op basis van lichtgewicht, ‘slapende’ schimmels, die prima kunnen worden bewaard en meegenomen op lange ruimtereizen. Bij aankomst wordt dan een basisstructuur uitgevouwen, water toegevoegd, waarna de schimmels rond dat raamwerk kunnen groeien tot een volledig functioneel onderkomen. En dat alles onder afgesloten condities om verontreiniging van het Marsoppervlak te voorkomen.
En zo ontstaat een zichzelf vormende constructie van lichtgewicht, vezelmateriaal met volgens NASA uitstekende mechanische eigenschappen. Het materiaal kan droog, nat, bevroren met water worden toegepast of omgezet tot composietmateriaal met isolerende eigenschappen; beschermend tegen straling en dampdicht. Het materiaal (re)produceert zichzelf, zodat de habitat in de toekomst kan worden uitgebreid en zichzelf bovendien kan herstellen.
Bio-engineering
Myceliummaterialen worden al com
mercieel geproduceerd. Ze zijn gekende
isolatoren en hebben brandvertragende eigenschappen. Aangezien mycelium normaal enzymen uitscheidt, zou het mogelijk moeten zijn om ze zodanig met bio-engineering biologisch aan te passen, dat ze bruikbare materialen gaan aanmaken, zoals bioplastics of
latex en op die manier een biocomposiet vormen. Op die manier kan een op mycelium
bouwwerk kunnen worden gemaakt,
bestaande uit ‘stand alone’ mycelium
composiet, al dan niet in combinatie met
gesinterd regoliet (oppervlakte materiaal van Mars) 1 . En als de onderkomen inmid
dels door mensen zijn bewoond, kunnen er extra structuren worden gekweekt met grondstoffen van door missie geproduceerde organische afvalstromen. Mits goed beschermd, kunnen de mycomaterialen een lange levensduur hebben, maar aan het einde van de levenscyclus kan het materiaal als mest worden gebruikt voor landbouw op de planeet.
Drielagige koepel
Ook een mycelium moet kunnen eten en ademen. Dat is waar zogenaamde cyanobacteriën op het toneel verschijnen: een bacteriesoort die energie van de zon kan gebruiken om water en kooldioxide om te zetten in zuurstof en voedingsstoffen. NASA stelt zich een habitatconcept voor met een drielagige koepel. De buitenste laag bestaat uit bevroren water, ijs dus, dat uit de Marsbodem kan worden gewonnen. Dat water dient als bescherming tegen straling en druppelt naar de tweede laag, waar de cyanobacteriën zich bevinden. Deze laag kan dat water opnemen en er vindt fotosynthese plaats onder invloed van het buitenlicht dat door de ijzige laag schijnt. Deze fotosynthese zocht voor de productie van zuurstof voor en voedingsstoffen voor de myceliumlaag: de eigenlijke constructie. Volgens Rothschild is dit nog maar het begin. Mycelium kan bijvoorbeeld ook worden gebruikt voor waterfiltratie, vochtigheidsregeling, bioluminescente verlichting en voor biomining-systemen die mineralen uit afvalwater kunnen halen (een ander project dat actief is in het Rothschild-laboratorium) en self healing onderkomens die zichzelf kunnen repareren. En al die technieken kunnen ook waardevol zijn voor toepassing op aarde. ‘Als we ontwerpen voor de ruimte, zijn we vrij om te experimenteren met nieuwe ideeën en materialen met veel meer vrijheid dan we op aarde zouden doen’, zei Rothschild op de NASA-website. ‘En nadat deze prototypes zijn ontworpen voor andere werelden, kunnen we ze terugbrengen naar de onze.’
1 Regoliet is een laag losse, heterogene op
pervlakkige afzettingen die massief gesteente bedekken. Het bestaat uit stof, zand, gebroken gesteente en andere soortgelijke materialen en is onder meer aanwezig op aarde, de maan, Mars en op sommige asteroïden. Er wordt aangenomen dat regoliet kan worden gebruikt als constructiemateriaal, bijvoorbeeld voor het bouwen van constructies en onderkomens, waardoor menselijke missies naar de maan of naar Mars minder gecompliceerd zouden worden.
Meer bij NASA>
Zie ook :
‘A new approach to biomining: Bioengineering surfaces for metal recovery from aqueous solutions’>
Direct Formation of Structural Components Using a Martian Soil Simulant>

Mikrocentrum, VOM en Vereniging ION hebben in navolging van de aangescherpte regels rondom het Coronavirus, besloten het kennis- en netwerkevent Materials+Eurofinish+Surface 2020 te verplaatsen naar 26 en 27 mei 2021. De huidige ontwikkelingen en de onzekerheid die dit voor het welzijn van alle betrokkenen met zich meebrengt, heeft de organisatie dit besluit doen nemen.
‘Het welzijn van de bezoekers, de exposanten en alle andere betrokkenen heeft voor ons als organisatie de hoogste prioriteit. Als organisatoren hebben we vanaf het begin van de samenwerking, de intentie en de wens om het vernieuwde en gecombineerde event tot een groot succes te maken. Gezien de huidige ontwikkelingen zal het moeilijk zijn om die doelstelling in juni van dit jaar te realiseren. De verscherpte regels door de overheid in combinatie met diverse geuite zorgen door exposanten gaf ons de doorslag om het event te verplaatsen.’
Aldus organisatoren Timo van Leent (Mikrocentrum), Veerle Fincken (VOM) en Egbert Stremmelaar (Vereniging ION).
‘Het is nu belangrijk dat we er als maatschappij voor zorgen dat we zo gezond mogelijk door deze komende periode heen komen. Vandaar dat we ervoor gekozen hebben het event te verschuiven naar 2021. Zo kunnen we er alsnog een geweldig, grensoverschrijdend kennis- en netwerkevent van maken!’
Het concept blijft ongewijzigd, evenals de locatie. De nieuwe datum is vastgelegd op woensdag 26 en donderdag 27 mei 2021 op dezelfde locatie: NH Conference Centre Koningshof te Veldhoven (Nederland). Het concept, de opzet van de beursvloer en de beoogde thema’s in lezingenprogramma blijven, voor zover mogelijk, gewaarborgd. Inmiddels is er vanuit de organisatie contact gezocht met alle exposanten en wordt per deelnemer gekeken naar de wensen en mogelijkheden.
Over Materials+Eurofinish+Surface
Materials+Eurofinish+Surface is het kennis- en netwerkevent waar men alle aspecten ontdekt voor een goed en duurzaam eindproduct. Bezoekers vinden een compleet overzicht van de laatste ontwikkelingen binnen de gehele keten; van grondstof tot en met gerealiseerd product. Denk aan hierbij aan materiaalkunde, analysetechnieken, verbindingstechnieken, productontwikkeling en oppervlaktetechnieken. Materials+Eurofinish+Surface is dan ook de centrale ontmoetingsplaats waar Nederlandse en Belgische specialisten elkaar ontmoeten.
Webinar en meer informatie
Momenteel wordt gezocht naar digitale oplossingen om virtuele interactie mogelijk te maken voor alle professionals die op zoek zijn naar info over materialen, coatings of mogelijke marktspelers. Meer informatie over de invulling hiervan en over Materials+Eurofinish+Surface 2021 is binnenkort te vinden op:
www.materials-eurofinish-surface.com

Fosfaatglas met vliegas toont onverwachte eigenschappen
Glas is transparant en sterk, maar de smelttemperatuur is hoog en het materiaal is broos. Uit promotieonderzoek van Clarissa Justino de Lima blijkt dat het mogelijk is de eigenschappen te verbeteren. Ze ontwikkelde een glas uit fosfaat en vliegas met een lage smelttemperatuur en een ongewone sterkte. Op 30 maart verdedigde Clarissa Justino de Lima haar proefschrift ‘Innovative low-melting glass compositions containing fly ash and blast furnace slag’.
Standaard glas bestaat voor een belangrijk deel uit silica of siliciumdoxide en heeft een ongelooflijke theoretische sterkte van wel 7000 MPa. Maar helaas, door zijn broosheid haalt het een praktische sterkte van slechts 35 tot 70 MPa. Breekbaarheid blijft de achilleshiel, ook bij architectonische toepassingen, zoals glasstenen. Zijn er geen mogelijkheden om dat te verbeteren, vroeg De Lima zich af? Zij experimenteerde in het laboratorium met nieuwe glassamen
stellingen, om te beginnen met fosforpentoxide (P2O5) en een beetje vliegas en hoogovenslak - afvalproducten uit verbrandings- en hoogovens. Helemaal nieuw is fosfaatglas niet. Al sinds de jaren ’50 zijn geavanceerde
glassoorten ontwikkeld met fosfaat, dat zorgt voor lagere smelttemperatuur en vermindering van de viscositeit. Een belangrijk probleem is volgens De Lima dat fosfaat veel water absorbeert. Het geproduceerde glas bleek buitengewoon hygroscopisch. Om de kwaliteit te testen dompelde ze het geproduceerde werkstuk een maand lang onder in water. Resultaat: het glaswerk verloor 100 procent van zijn gewicht, alle fosfaat was eruit verdwenen. Toen ze een proef deed met glas met een gehalte van 85 procent kaliumfosfaat, was na een maand de helft van de massa verdwenen. Volgens De Lima Het was het geen glas meer, het was een soort gel. Dat veranderde toen ze het gehalte kaliumfosfaat verlaagde naar een percentage van 50 tot 75 procent en tenminste 15 procent aluminiumoxide (Al 2 O 3 ) toevoegde, ter vergroting van de waterbestendigheid. Verder krikte ze het gehalte vliegas en hoogovenslak flink op. In dit geval bleek het verlies aan massa verwaarloosbaar.
Transparantie
Vliegas en hoogovenslak zijn veelgebruikt als toeslagstof in cement, maar bleken bij dit experiment ook prima geschikt voor gebruik in glas. De transparantie ervan blijkt pas te worden aangetast bij een gehalte van meer dan 35 procent. Bij een hoger percentage zorgt de vliegas voor kristallisatie bij het afkoelen - en dat is niet gunstig voor de sterkte en de transparantie. Bij verandering van de samenstelling van de toeslagmaterialen zag De Lima ook de kleuren van het glas veranderden. Ze produceerde kleurloos, maar ook bruin, blauw, geel en groen glas. De diverse mengsels fosfaatglas die uit de proeven rolden hadden alvast één prettige eigenschap: een lage smelttemperatuur. Die bedroeg zo’n 1200°C in plaats van 1500 tot 1600°C zoals borosilicaat- en natronkalkglas. Dat scheelt fors in de energiekosten en in milieubelasting. De prijs is bovendien per kilo grofweg drie maal lager dan genoemde glassoorten. In potentie is dus een interessant product, mits de mechanische eigenschappen voldoen.
3D-printer
De Lima voerde laboratoriumtests uit om die eigenschappen vast te stellen. Daaruit bleek dat de elasticiteitsmodulus en hardheid van het geproduceerde fosfaatglas lager zijn dan die van standaard silicaatglas, maar de breukbestendigheid van sommige mengsels is hoger. Dat kan van pas komen bij het gebruik van fosfaatglas als constructiemateriaal. Ook de thermische stabiliteit is hoog, terwijl de uitzetting beperkt blijft. Sommige mengsels zouden daardoor geschikt kunnen zijn voor gebruik in de 3D-printer.
Anisotroop
Het labonderzoek leverde nog een interessante vondst op. Bij bepaalde samenstellingen kan het ontwikkelde fosfaatglas - anders elke andere glassoort - anisotroop zijn. Dat is volgens De Lima uitzonderlijk, want het betekent dat het in de ene richting een grote deformatie zou kunnen hebben, terwijl er in andere richting slechts een kleine vervorming is. Het kan dus betekenen dat het veel sterker in de ene richting is dan in de andere.
Opmerkelijk is bovendien dat het anisotrope glas zijn transparantie behield. In theorie maakt dit glas mogelijk met buitengewone eigenschappen. Een constructie vervaardigd uit dit type fosfaatglas zou door slimme oriëntatie bestand kunnen zijn tegen specifieke belastingen. Is het daarmee geschikt voor toepassingen in de bouw, bijvoorbeeld als glazen bouwstenen of elementen voor de bouw van bruggen? Vervolgonderzoek zal dat moeten uitwijzen.
Tekst: TUDelft>
Innovative low-melting glass compositions containing fly ash and blast furnace slag
